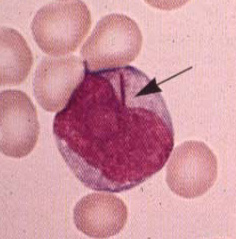

|
Nucleus : ขอบเขตของ nucleus มักพับหรือมีหยัก
Nuclear chromatin : nuclear chromatin จะละเอียด และมี
nucleolar กับ nuclear membranes ไม่ชัดเจน
Cytoplasm : cytoplasm จะมีปริมาณมากกว่าใน lymphoblast
และอาจจะมี fine granules ซึ่งมี ลักษณะเหมือนกับที่เห็นใน promyelocytes
ปกติ
(promyelocyte ใน acute promyelocytic leukemia (ANLL-M3) จะเป็น abnormal
(hypergranular) promyelocyte )
Auer rod (ลูกศรชี้) : เป็นแท่งของ Dysplastic lysosomes
ถือเป็น pathognomonic signs ของ ANLL โดยย้อมติดสีเป็นแท่งสีชมพู-แดง
พบใน ANLL ประมาณ 10-30% ไม่พบใน ALL หรือโรคอื่น
|

